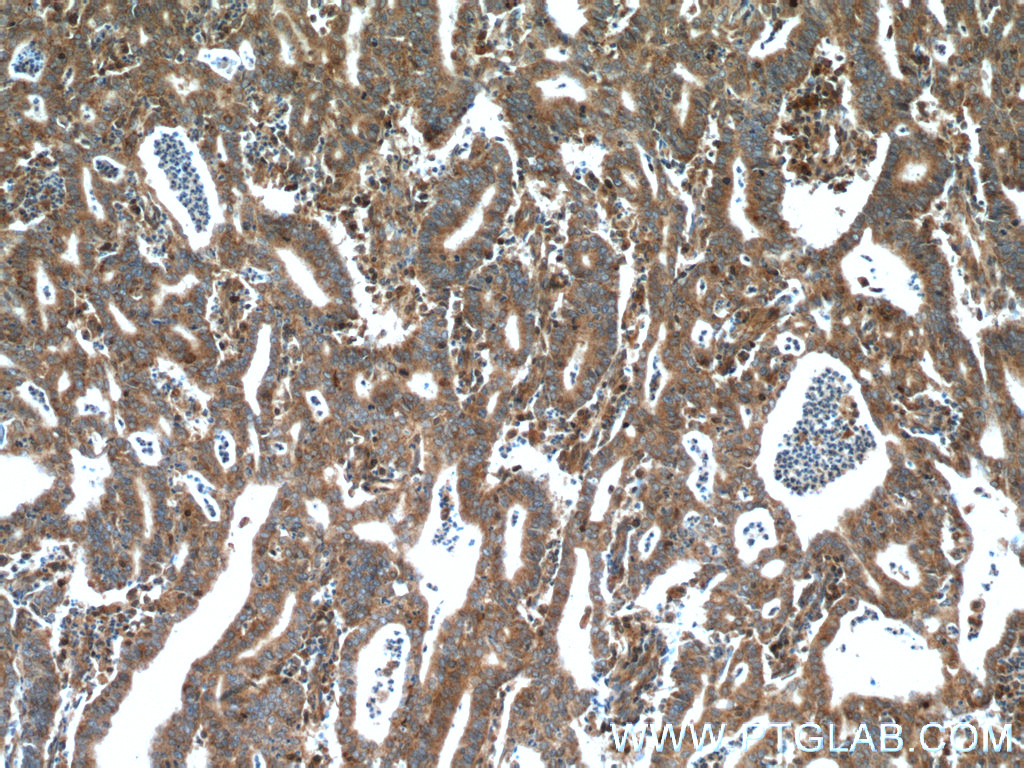
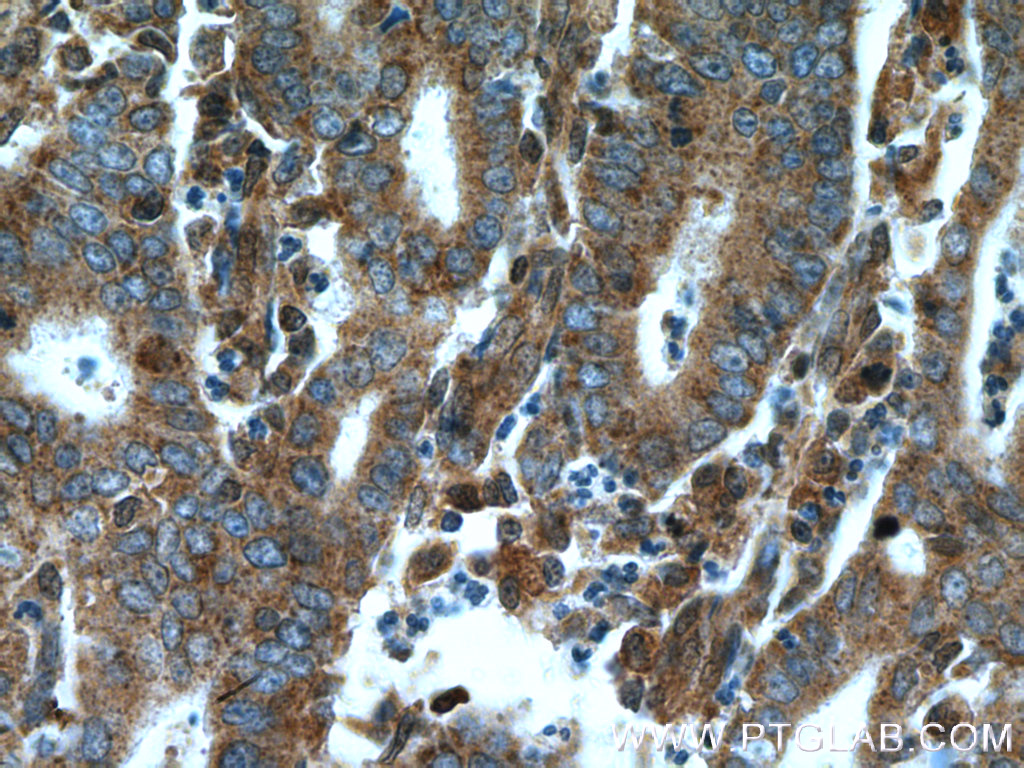

验证数据展示
经过测试的应用
| Positive WB detected in | Jurkat cells, C2C12 cells, MOLT-4 cells, NIH/3T3 cells, K-562 cells |
| Positive IP detected in | Jurkat cells |
| Positive IHC detected in | human urothelial carcinoma tissue, human endometrial cancer tissue, human lung cancer tissue, mouse colon tissue, rat testis tissue Note: suggested antigen retrieval with TE buffer pH 9.0; (*) Alternatively, antigen retrieval may be performed with citrate buffer pH 6.0 |
| Positive IF/ICC detected in | HeLa cells |
| Positive FC (Intra) detected in | HeLa cells |
推荐稀释比
| 应用 | 推荐稀释比 |
|---|---|
| Western Blot (WB) | WB : 1:1000-1:8000 |
| Immunoprecipitation (IP) | IP : 0.5-4.0 ug for 1.0-3.0 mg of total protein lysate |
| Immunohistochemistry (IHC) | IHC : 1:250-1:1000 |
| Immunofluorescence (IF)/ICC | IF/ICC : 1:200-1:800 |
| Flow Cytometry (FC) (INTRA) | FC (INTRA) : 0.25 ug per 10^6 cells in a 100 µl suspension |
| It is recommended that this reagent should be titrated in each testing system to obtain optimal results. | |
| Sample-dependent, Check data in validation data gallery. | |
产品信息
14052-1-AP targets CDK6 in WB, IHC, IF/ICC, FC (Intra), IP, CoIP, ELISA applications and shows reactivity with human, mouse, rat samples.
| 经测试应用 | WB, IHC, IF/ICC, FC (Intra), IP, ELISA Application Description |
| 文献引用应用 | WB, IHC, IF, FC (Intra), IP, CoIP |
| 经测试反应性 | human, mouse, rat |
| 文献引用反应性 | human, mouse, rat, zebrafish, goat |
| 免疫原 |
CatNo: Ag5275 Product name: Recombinant human CDK6 protein Source: e coli.-derived, PGEX-4T Tag: GST Domain: 1-326 aa of BC027989 Sequence: MEKDGLCRADQQYECVAEIGEGAYGKVFKARDLKNGGRFVALKRVRVQTGEEGMPLSTIREVAVLRHLETFEHPNVVRLFDVCTVSRTDRETKLTLVFEHVDQDLTTYLDKVPEPGVPTETIKDMMFQLLRGLDFLHSHRVVHRDLKPQNILVTSSGQIKLADFGLARIYSFQMALTSVVVTLWYRAPEVLLQSSYATPVDLWSVGCIFAEMFRRKPLFRGSSDVDQLGKILDVIGLPGEEDWPRDVALPRQAFHSKSAQPIEKFVTDIDELGKDLLLKCLTFNPAKRISAYSALSHPYFQDLERCKENLDSHLPPSQNTSELNTA 种属同源性预测 |
| 宿主/亚型 | Rabbit / IgG |
| 抗体类别 | Polyclonal |
| 产品类型 | Antibody |
| 全称 | cyclin-dependent kinase 6 |
| 别名 | CDKN6, Cell division protein kinase 6, Cyclin dependent kinase 6, Cyclin-dependent kinase 6, EC:2.7.11.22 |
| 计算分子量 | 326 aa, 36 kDa |
| 观测分子量 | 36-40 kDa |
| GenBank蛋白编号 | BC027989 |
| 基因名称 | CDK6 |
| Gene ID (NCBI) | 1021 |
| RRID | AB_10642144 |
| 偶联类型 | Unconjugated |
| 形式 | Liquid |
| 纯化方式 | Antigen affinity purification |
| UNIPROT ID | Q00534 |
| 储存缓冲液 | PBS with 0.02% sodium azide and 50% glycerol, pH 7.3. |
| 储存条件 | Store at -20°C. Stable for one year after shipment. Aliquoting is unnecessary for -20oC storage. |
背景介绍
Cyclin-dependent kinase 6 (CDK6) is an enzyme belonging to the CDK family. CDK6 is a catalytic subunit of a
protein kinase complex that is essential for progression through the G1 phase of the cell cycle and G1/S transition,
thus activating cell proliferation. CDK6 partners with cyclins to phosphorylate the retinoblastoma (pRb) protein to
release its binding partner E2F; a transcription factor that drives gene expression necessary for DNA replication
(PMID: 8114739). CDK6 was long thought of as a redundant homolog of CDK4 as they perform similar roles in cell
cycle progression. But recently it has become apparent that CDK6 and CDK4 differ in tissue-specific functions,
where CDK6 plays a role in differentiation (PMID: 16410727) but also in contribution to tumor development.
What is the molecular weight of CDK6?
The molecular weight of CDK6 is approximately 36-40 kDa (PMID: 23563707, 8114739).
What is the subcellular localization of CDK6?
CDK6 is ubiquitously expressed through the nucleus and cytoplasm. However, the most active complexes are
located in the nuclei of proliferating cells.
What is the expression pattern of CDK6?
CDK6 activity first occurs midway through the G1 phase. Its expression is regulated by D-type cyclins and
members of the INK4 family of CDK inhibitors (PMID: 7739547).
What is CDK6's role in cancer?
CDK6 is involved in a critical regulatory point in the cell cycle and so is found to be unbalanced in approximately
80-90% of tumors (PMID: 23356980). Loss of cell cycle control is the initial step in the development of the
hallmarks of cancer, such as sustained proliferative signaling and dysregulated cellular energetics. Deregulation
of CDK6 has an important role in lymphoma by increasing angiogenesis (PMID: 23948297) and upregulated CDK6
expression is also associated with a poor clinical prognosis in medulloblastoma (PMID: 23172372).
实验方案
| Product Specific Protocols | |
|---|---|
| FC protocol for CDK6 antibody 14052-1-AP | Download protocol |
| IF protocol for CDK6 antibody 14052-1-AP | Download protocol |
| IHC protocol for CDK6 antibody 14052-1-AP | Download protocol |
| IP protocol for CDK6 antibody 14052-1-AP | Download protocol |
| WB protocol for CDK6 antibody 14052-1-AP | Download protocol |
| Standard Protocols | |
|---|---|
| Click here to view our Standard Protocols |
发表文章
| Species | Application | Title |
|---|---|---|
Nat Commun The RNA-binding protein LRPPRC promotes resistance to CDK4/6 inhibition in lung cancer | ||
Acta Pharm Sin B SAE1 promotes tumor cell malignancy via SUMOylation and liquid-liquid phase separation facilitated nuclear export of p27 | ||
Genome Biol Single-cell transcriptomics reveals multiple chemoresistant properties in leukemic stem and progenitor cells in pediatric AML | ||
Nat Commun ICAM1 initiates CTC cluster formation and trans-endothelial migration in lung metastasis of breast cancer. | ||
Nat Commun Identification of predictors of drug sensitivity using patient-derived models of esophageal squamous cell carcinoma. |